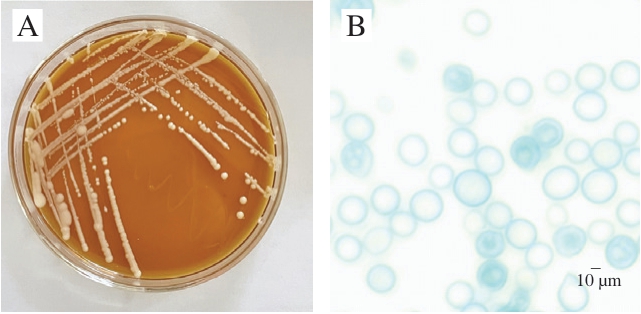

生物胺是一类低分子质量含氮有机化合物,主要由氨基酸通过微生物脱羧作用生成,广泛存在于发酵食品中。过量摄入生物胺可能引发头痛、血压升高、皮疹、心律失常甚至过敏反应,尤其对代谢能力较差的人群(如服用单胺氧化酶抑制剂的患者)危害更为严重[1]。美国食品安全监管机构已对生物胺含量设定推荐限值(例如,鱼制品中组胺含量不应超过50 mg/kg)。
在发酵肉制品(如干发酵香肠、腊肉、酸鱼和酸肉等)中,生物胺的积累尤为显著。例如,在酸鱼发酵过程中,与新鲜鱼肉相比,其腐胺、尸胺、酪胺含量显著增加[2]。不同地区传统酸肉制品的生物胺含量存在显著差异,其中苗家酸肉的生物胺总量最低(961.20 mg/kg),而榕江酸肉(3 201.97 mg/kg)、包谷酸肉(4 673.85 mg/kg)和黎平酸肉(4 687.37 mg/kg)生物胺总量均显著高于食品安全限值(1 000 mg/kg)[3]。因此,如何有效控制发酵肉制品中生物胺的积累成为保障食品安全的重要课题。
传统的降低生物胺含量方法(如化学添加剂或物理处理)会影响食品质量且缺乏特异性[4]。研究发现,乳酸菌和酵母菌等多种微生物具有降解生物胺的能力。例如,人工接种乳酸菌发酵耿马酸肉能够有效降低生物胺总量[5]。沃氏葡萄球菌(Staphylococcus warneri)对8 种常见的生物胺均有一定的降解作用[6]。采用乳酸菌与酵母菌混合菌种进行协同发酵,能够显著抑制牛肉发酵过程中生物胺的生成,包括组胺、酪胺、色胺及丁二胺等[7]。从发酵谷物中分离出的奥默柯达酵母(Kodamaea ohmeri)对特定生物胺(如腐胺)的降解率可达39%[8],但其具体的生物胺降解机制尚未明确。目前,尚缺乏针对酵母中胺氧化酶、脱氢酶等关键降解酶的深入鉴定和功能验证,阻碍了其在生物胺控制领域的应用开发。
本研究以具有生物胺降解功能的酿酒酵母(Saccharomyces cerevisiae)为研究对象,通过转录组与代谢组分析,探索其在生物胺降解过程中的潜在机制和关键代谢路径。与传统降解微生物(如乳酸菌或非常规酵母)相比,酿酒酵母在食品适应性、安全性和发酵稳定性等方面均具有显著优势[9]。因此,增强其降解能力不仅有助于拓展其工业应用边界,也为发酵肉制品中生物胺的控制提供了更加安全、自然和高效的解决方案。同时,本研究在多组学分析的基础上识别并解析了多个与胺类降解相关的关键基因与代谢物,这不仅为发酵肉制品的食品安全控制提供了可行的微生物策略,也为未来微生物功能定向改造提供了理论基础和技术支撑。
1 材料与方法
1.1 材料与试剂
野生酵母菌S. cerevisiae Hl为本实验室保藏;人工选育酵母菌S. cerevisiae Z5通过复合诱变选育。
酵母浸出粉胨葡萄糖(yeast extract peptone dextrose,YPD)琼脂培养基、YPD液体培养基 青岛海博生物技术有限公司;色胺、苯乙胺、腐胺、组胺、酪胺、尸胺、精胺、亚精胺标准品(均为色谱纯)广州佳途科技股份有限公司;甲醇、乙腈(均为色谱纯)德国Meker公司;乙酸 上海易恩化学技术有限公司;甲酸铵(色谱纯) 阿拉丁试剂(上海)有限公司;多胺氧化酶活性检测试剂盒 北京索莱宝科技有限公司。
1.2 仪器与设备
Q Exactive HF-X质谱仪、Vanquish超高效液相色谱仪美国Thermo Scientific公司;SpectraMax ABS Plus酶标仪上海美谷分子仪器有限公司。
1.3 方法
1.3.1 菌株培养
将野生酵母菌和人工选育酵母菌的冷冻或斜面培养物接种到YPD琼脂培养基上,在28 ℃下培养直至形成单菌落。选择单菌落转移至50 mL YPD液体培养基中,在28 ℃下培养12 h,作为应用菌株。
以2%的接种量接种至含有8 种生物胺的YPD液体培养基中,以未接种菌株的含生物胺YPD培养基作为空白对照组。2 组中各生物胺的质量浓度均为100 mg/L。
1.3.2 转录组分析
1.3.2.1 样品收集和准备
分别收集在添加和不添加生物胺的YPD液体培养基中培养48 h的野生酵母菌S.cerevisiae Hl和人工选育酵母菌S.cerevisiae Z5,4 ℃、12 000 r/min离心10 min后,迅速收集菌体沉淀,并立即将其投入液氮中进行快速冷冻。之后,将冷冻的菌体转移至-80 ℃冰箱中保存,以备后续使用。共设置4 个处理组,分别为Z5(人工选育S. cerevisiae Z5)、Z5_A(100 mg/L生物胺胁迫的人工选育S. cerevisiae Z5)、Hl(野生S. cerevisiae Hl)、Hl_A(100 mg/L生物胺胁迫的野生S. cerevisiae Hl)。每个处理组包含3 个生物学重复,共12 个样本。cDNA文库由武汉迈维生物技术有限公司在Illumina测序平台上进行测序。
1.3.2.2 数据质量控制与参考基因比对
使用fastp进行数据质量控制,去除含有接头的Reads。在以下条件下去除配对Reads:当任何测序Reads中N的数量超过该Reads长度的10%,以及任何测序Reads中低质量碱基(Q≤20)超过该Reads长度的50%。后续分析基于Clean Reads进行。使用HISAT构建索引,并将Clean Reads比对到参考基因组。
1.3.2.3 基因表达水平定量
外显子每千碱基片段百万比(fragments per kilobase of exon model per million mapped fragments,FPKM)是目前估计基因表达水平最常用的方法。使用featureCounts软件进行基因比对统计,随后基于基因长度计算每个基因的FPKM。
1.3.2.4 差异基因表达与富集
使用DESeq2软件进行2 组之间的差异基因表达分析,并应用Benjamini & Hochberg法校正P值,以校正后的P值和差异倍数(fold change,FC)作为显著差异表达的阈值。
基于超几何检验,对京都基因与基因组百科全书(Kyoto Encyclopedia of Genes and Genomes,KEGG)通路进行富集分析[10],对基因本体(gene ontology,GO)术语进行基于GO项的分析。
1.3.3 代谢组分析
1.3.3.1 样品制备与提取
样品制备方法与1.3.2.1节相同。将保存在-80 ℃冰箱中的样品在冰上解冻,解冻后的样品通过研磨机(30 Hz)研磨20 s,向40 mg样品中加入400 μL体积分数80%甲醇溶液,并涡旋3 min,将样品置于液氮中5 min,然后在干冰上放置5 min,之后在冰上解冻并涡旋2 min,冻融循环共重复3 次。样品在12 000 r/min下离心10 min(4 ℃),收集300 μL上清液,并在-20 ℃下放置30 min,然后将样品在12 000 r/min下离心3 min(4 ℃),取200 μL上清液进行液相色谱-串联质谱(liquid chromatography-tandem mass spectrometry,LCMS/MS)分析。
1.3.3.2 LC条件
色谱柱:Waters ACQUITY Premier HSS T3(2.1 mm×100 mm,1.8 µm);流动相A:0.1%甲酸溶液;流动相B:0.1%甲酸-乙腈;柱温40 ℃;流速0.4 mL/min;进样量4 μL。梯度洗脱程序:0~2 min,5%~20% B;2~5 min,20%~60% B;5~6 min,60%~99% B;6~7.5 min,99% B;7.5~7.6 min,99%~5% B;7.6~10 min,5% B。
1.3.3.3 MS条件
使用电喷雾电离离子源,在正、负离子模式下进行,m/z 75~1 000全扫描分析,分辨率35 000。离子喷射电压:正模式为3.5 kV,负模式为3.2 kV;鞘气流速30 arb;辅助气流速5 arb;离子传输管温度320 ℃;蒸发器温度300 ℃;碰撞能量:30、40、50 V;排除持续时间3 s。
1.3.3.4 主成分分析(principal component analysis,PCA)
使用R(http://www.r-project.org)内的统计函数prcomp执行无监督PCA。在无监督PCA之前,对数据进行单位方差缩放。
1.3.3.5 差异代谢物选择
通过变量投影重要性(variable importance in projection,VIP)(VIP>1)和P值(P<0.05,Student’s t检验)确定。VIP值从正交偏最小二乘判别分析(orthogonal partial least squares-discriminant analysis,OPLS-DA)结果中提取,该结果包括得分图和置换图,使用R包MetaboAnalystR生成。
1.3.3.6 KEGG注释和富集分析
使用KEGG Compound数据库(http://www.kegg.jp/keg)对鉴定的代谢物进行注释。
1.3.4 多胺氧化酶活性测定
将野生酵母菌株、人工选育酵母菌株、生物胺胁迫下的野生酵母菌株及人工选育酵母菌株在YPD液体培养基中充分活化2 次,按照酵母菌数量与提取液体积比例500∶1~1 000∶1(105 cells/mL)混合,冰浴超声波破碎细胞或细菌(功率200 W,超声3 s,间隔7 s,总时间3 min),4 ℃、10 000×g离心10 min,取上清,置于冰上待测。按照多胺氧化酶活性检测试剂盒说明书要求配制反应体系,用酶标仪于500 nm波长处测定吸光度,以不加菌体的测定液作为对照。
酶活力单位定义:在每毫升反应体系中,每105 个细胞或细菌每分钟催化,在500 nm波长处,吸光度增加0.000 5定义为一个酶活力单位。多胺氧化酶活力按下式计算:
式中:F为稀释倍数。
1.4 数据处理
转录组数据采用fastp、hisat2、featureCounts、DESeq2软件进行分析。代谢组数据采用R进行分析。采用Origin软件作图。
2 结果与分析
2.1 人工选育酵母菌S. cerevisiae Z5的培养特征
如图1所示,S. cerevisiae Z5在YPD固体培养基上呈乳白色,湿润、隆起,菌落整体黏稠,表面较光滑,容易挑起,质地较均匀,正反面与边缘及中心部位的颜色均一。细胞显微形态为球状,出芽生殖。
图1 S.cerevisiae Z5菌落形态(A)和显微形态(×1 000)(B)
Fig.1 Colony morphology (A) and microscopic morphology (×1 000) (B) of S.cerevisiae Z5
2.2 转录组分析结果
2.2.1 测序数据质量评估
如表1所示,对4 组样本(Z5、Z5_A、Hl、Hl_A)进行转录组测序,共获得108.61 Gb Clean Data,各样品Clean Data均达到7 Gb,经质量控制后,Clean Reads占比均大于98.3%,Q30均大于93%,表明测序数据质量良好。GC含量在44.19%~45.50%之间,说明各样本的GC含量分布合理,无污染。
表1 转录组测序质量评估
Table 1 Quality assessment of transcriptome sequencing

注:Q20.质量值≥20的碱基占比;Q30.质量值≥30的碱基占比。
组别原始数据Clean Reads Clean Base(G)Q20/%Q30/%GC含量/%Hl-159 887 47259 209 5028.8897.8993.4544.19 Hl-269 017 16068 086 40410.2198.3894.9145.18 Hl-351 413 85250 690 5587.6098.2494.5045.50 Hl_A-1 85 599 42684 462 30612.6798.4395.0744.32 Hl_A-2 66 496 73865 427 1529.8198.3594.9144.47 Hl_A-3 72 737 67471 681 82610.7598.4094.9744.54 Z5-152 405 49051 729 3567.7698.2394.4745.33 Z5-261 676 46860 809 8489.1298.2694.5545.08 Z5-352 312 776515941527.7498.2994.6744.54 Z5_A-1 47 890 26246 941 0087.0498.3995.0544.47 Z5_A-2 55 441 29854 502 4108.1898.3294.8244.38 Z5_A-3 59 986 10059 020 8308.8598.3694.9144.49
2.2.2 差异表达基因分析
基于P<0.05和|log2FC|>1定义差异表达基因。如图2所示,在Hl_A与Hl的比较中,鉴定出3 165 个差异表达基因,包括1 627 个上调基因和1 538 个下调基因。在Z5_A与Hl的比较中,鉴定出3 012 个差异表达基因,包括1 586 个上调基因和1 516 个下调基因。在Hl与Z5的比较中,鉴定出824 个差异表达基因,包括220 个上调基因和604 个下调基因。


图2 Hl_A与Hl、Hl与Z5、Z5_A与Hl的差异表达基因火山图
Fig.2 Volcano plots of differentially expression genes between Hl_A and Hl, Hl and Z5, Z5_A and Hl
A.Hl_A vs.Hl;B.Hl vs.Z5;C.Z5_A vs.Hl。图3、4、6同。
2.2.3 差异表达基因GO分析
为更好地理解与诱变和生物胺胁迫相关的功能类别,进行GO富集分析。如图3所示,在Hl_A与Hl的比较中,核糖体的生物发生、羧酸代谢过程、酮酸代谢过程、有机酸代谢过程和细胞质翻译的差异最为显著。对于Z5_A与Hl的比较,核糖核蛋白复合物生物合成的差异最为显著。在Hl与Z5的比较中,核糖体的生物发生、rRNA加工、核糖体小亚基(small subunit,SSU)生物合成、核糖核蛋白复合体生物合成和细胞质翻译的差异最为显著。


图3 Hl_A与Hl、Hl与Z5、Z5_A与Hl的差异表达基因GO富集散点图
Fig.3 Gene ontology enrichment scatter plots of differentially expressed genes between Hl_A and Hl, Hl and Z5, Z5_A and Hl
LSU.大亚基(large subunit)。
2.2.4 差异表达基因KEGG分析
通过KEGG生物通路分类和富集分析可获得差异表达基因的表达通路。如图4所示,在KEGG富集类别中,代谢类别在4 个处理组条件下表达最高,分别占Hl_A与Hl比较的63.74%、Z5_A与Hl比较的79.85%和Hl与Z5比较的74.58%。差异表达基因还与细胞过程、遗传信息处理等其他功能类别相关,包括核糖体、过氧化物酶体等通路。


图4 Hl_A与Hl、Hl与Z5、Z5_A与Hl的差异表达基因KEGG富集散点图
Fig.4 Kyoto Encyclopedia of Genes and Genomes (KEGG) enrichment scatter plots of differentially expressed genes between Hl_A and Hl,Hl and Z5, Z5_A and Hl
MAPK.丝裂原活化蛋白激酶(mitogen-activated protein kinase)。
所有对比组中最显著富集的通路均为代谢通路(ko01100)和次生代谢产物合成(ko01110),这2 个通路的显著富集表明,S. cerevisiae Z5通过整体代谢网络的重构与调节响应生物胺的毒性压力。尤其是代谢通路(ko01100)富集基因数量最多(如Hl_A与Hl比较中多达465 个基因),这暗示整个代谢系统参与了生物胺的代谢、排毒或防御响应。KEGG通路ko01100是全基因组范围的代谢信息汇总通路,其变化常作为代谢重构的重要指标[11]。
代谢通路中,特别值得关注的是与氨基酸代谢相关的通路,其中显著富集的包括半胱氨酸和甲硫氨酸代谢(ko00270)、谷氨酸和天冬氨酸代谢(ko00250)、精氨酸和脯氨酸代谢(k o 0 0 3 3 0)、色氨酸代谢(ko00380)等。半胱氨酸和甲硫氨酸代谢(ko00270)这一通路产生活性硫代谢产物(如S-腺苷甲硫氨酸(S-adenosylmethionine,SAM))不仅是许多脱氨反应的辅酶,也参与抗氧化反应,对抗生物胺代谢副产物的氧化应激。SAM是调控细胞解毒的关键分子[12]。谷氨酸、天冬氨酸代谢(ko00250)参与合成关键代谢物(如α-酮戊二酸、γ-氨基丁酸等),促进有毒氨基化合物的转化与降解[13]。精氨酸和脯氨酸代谢(ko00330)涉及一氧化氮信号通路及与氧化胺类物质的代谢协调,有研究[14]指出,此通路影响多胺转运与氧化还原稳态。色氨酸代谢(ko00380)中,色氨酸可转化为吲哚类或犬尿氨酸等,部分中间产物具有生物胺毒性缓解或细胞修复作用,如尼克酰胺腺嘌呤二核苷酸(nicotinamide adenine dinucleotide,NAD+)[15]。这些代谢通路之间可能形成协同网络,通过调节内源性氨基酸代谢调控相关酶表达(如胺脱氢酶、胺氧化酶),提升生物胺降解效率。谷胱甘肽代谢(ko00480)也比较关键,因其参与细胞氧化还原平衡维护,能中和生物胺代谢所产生的活性氧。谷胱甘肽是抗毒素系统的中心分子[16]。
在Hl与Z5比较中,差异表达基因也富集于核糖体(ko03010)。核糖体富集表明,人工选育影响了翻译效率与蛋白合成能力,尤其是涉及生物胺降解相关酶类的表达。研究[17]表明,在氧化胺降解过程中,需要大量的酶参与反应(如黄素腺嘌呤二核苷酸(flavin adenine dinucleotide,FAD)依赖性酶系),而蛋白合成能力的提升意味着菌株能快速响应胺类毒性并增强解毒机制。
2.3 代谢组分析结果
2.3.1 样本质控分析
使用LC-MS/MS系统进行非靶向代谢组分析。在所有样本中鉴定出2 375 种代谢物,并根据PCA清晰地分为4 组(图5)。

图5 Z5、Z5_A、Hl、Hl_A代谢物PCA图
Fig.5 Principal component analysis plot of metabolites of Z5, Z5_A,Hl, Hl_A
2.3.2 差异代谢物筛选
将OPLS-DA模型的VIP>1和P<0.05作为选择标准,对差异代谢物进行初步筛选。分析鉴定出Hl和Z5之间有407 种显著差异代谢物,包括177 种上调代谢物和230 种下调代谢物。此外,在Z5_A与Hl的比较中鉴定出376 种差异代谢物,包括194 种上调代谢物和182 种下调代谢物。在Hl_A与Hl的比较中鉴定出176 种差异代谢物,包括121 种上调代谢物和55 种下调代谢物。
2.3.3 差异代谢物功能注释及富集分析
基于差异代谢物结果,进行KEGG通路富集分析。富集因子为特定通路中差异代谢物数量与该通路中注释代谢物总数的比值,更高的富集因子反映更大的通路富集程度。P值越接近0,表明富集程度越显著。如图6所示,Hl_A与Hl的差异表达代谢物质主要富集在代谢途径、ABC转运蛋白、谷胱甘肽代谢、半胱氨酸和甲硫氨酸代谢、泛酸和辅酶A生物合成、β-丙氨酸代谢等。Hl与Z5的差异代谢物主要富集在氨基酸的生物合成、D-氨基酸代谢、碳代谢、精氨酸和脯氨酸代谢、磷酸戊糖途径、谷胱甘肽代谢等。Z5_A与Hl的差异代谢物富集在辅因子的生物合成、ABC转运蛋白、β-丙氨酸代谢、谷胱甘肽代谢、苯丙氨酸、酪氨酸和色氨酸生物合成、色氨酸代谢、泛酸和辅酶A生物合成、精氨酸和脯氨酸代谢等。

图6 Hl_A与Hl、Hl与Z5、Z5_A与Hl的差异代谢物KEGG富集图
Fig.6 KEGG enrichment plots of differentially expressed metabolites between Hl_A and Hl, Hl and Z5, Z5_A and Hl
如表2所示,Hl_A与Hl、Hl与Z5、Z5_A与Hl的显著差异代谢物主要包括氨基酸及其代谢物、有机酸及其衍生物、醛类、酮类、酯类、醇类、胺类等。在Hl与Z5比较中,Z5中的亚精胺、组胺、色胺、2-苯乙胺含量显著减少,说明人工选育菌种有效。在氨基酸及其代谢物类中,Z5_A的L-脯氨酸含量比野生菌株高。脯氨酸在多种微生物中作为兼具抗氧化和渗透调节的分子,能通过清除活性氧保护蛋白质和膜系统不被氧化破坏[18]。鹅肌肽也是Z5_A中含量显著上调的物质。鹅肌肽已被证实可稳定细胞内酶蛋白,尤其在氧化胁迫自由基富集环境下,有助于维持胺氧化酶的结构稳定性[19]。谷胱甘肽通过维持细胞内氧化还原平衡,间接影响胺氧化酶(如单胺氧化酶、多胺氧化酶)的活性。谷胱甘肽通过参与谷胱甘肽还原酶系统维持酶蛋白活性中心处于还原状态,从而延缓氧化失活。在植物乳植杆菌中,谷胱甘肽代谢途径相关基因的高表达被证实能显著提升生物胺的降解效率[20]。在Z5_A中,尽管整体谷胱甘肽含量变化不显著,但其稳定性可能正是其发挥保护性作用的核心机制。谷胱甘肽在生物胺胁迫下,其水平变化较小,表明其在Z5_A中的调节作用可能较为稳定。醛类、酮类、酯类物质中,5-氨基戊醛作为尸胺降解的核心中间产物通过含铜胺氧化酶的氧化脱氨作用转化而成。通过此途径,尸胺被转化为更稳定的醛类化合物,降低菌体环境内胺类积累风险。释放的H2O2通过细胞抗氧化系统(如谷胱甘肽)清除,避免了氧化应激。5-氨基戊醛在胁迫条件下升高,说明选育酵母菌S. cerevisiae Z5具有尸胺降解功能。
表2 Hl_A与Hl、Hl与Z5、Z5_A与Hl的部分显著差异代谢物
Table 2 Significantly differentially expressed metabolites between Hl_A and Hl, Hl and Z5, Z5_A and Hl

FC Hl_A vs.Hl Hl vs.Z5 Z5_A vs.Hl L-脯氨酸C00148 ko00330、ko00332、ko00470、ko00970、ko01100、ko01110、ko01230、ko020101.441 0.170 4.568鹅肌肽C01262ko00340、ko00410、ko011002.026 0.182 4.535谷胱甘肽C00051ko00270、ko00480、ko01100、ko01240、ko020101.305 0.897 1.081还原型物质物质分类cpd_IDko ID谷胱甘肽C00051ko00270、ko00480、ko01100、ko01240、ko020101.243 1.014 1.031 L-3-羟基犬尿氨酸C03227ko00380、ko01100、ko012401.786 0.194 1.197 L-色氨酸C00078氨基酸及其代谢物ko00260、ko00380、ko00400、ko00970、ko00999、ko01100、ko01110、ko01210、ko01230、ko01240 1.670 0.182 2.002组胺C00388ko00340、ko01100、ko011101.568 168.628 0.012酪胺C00483ko00350、ko00680、ko01100、ko01110、ko012400.698 0.703 0.579 D-脯氨酸有机酸及其衍生物C00763ko00330、ko00470、ko011001.407 0.183 4.036戊二酸C00489ko00071、ko00310、ko011001.459 0.615 1.357 SAM核苷酸及其代谢物C00019 ko00261、ko00270、ko00330、ko00999、ko01100、ko01110、ko01230、ko01240、ko04122 5.649 0.065 7.359 4-(谷氨酰胺基)丁酸醛类、酮类、酯类C15767ko00330、ko011000.463 2.817 4.103 5-氨基戊醛C12455ko00310、ko01100、ko011100.771 1.126 1.620亚精胺生物碱C00315ko00330、ko00410、ko00480、ko01100、ko020100.798 1.811 0.199 2-苯乙胺C05332ko00360、ko011001.319 137.432 0.006 4-胍基丁酰胺 醇类、胺类 C03078ko00330、ko011001.116 0.519 0.857泛酸辅酶和维生素C00864ko00410、ko00770、ko01100、ko01110、ko012401.450 0.260 5.171色胺色胺、胆碱、色素 C00398ko00380、ko01100、ko011101.448 115.564 0.007
2.4 多胺氧化酶活性比较
如图7所示,人工选育酵母菌S. cerevisiae Z5表现出明显较高的多胺氧化酶活力(3.85 U/105 cells),显著高于其他3 个组(P<0.05),这表明,人工选育增强了S. cerevisiae Z5对多胺的降解能力。在100 mg/L的生物胺胁迫下,Hl和Z5的多胺氧化酶活性均降低。Hl_A多胺氧化酶活力最低(0.87 U/105 cells),这反映了生物胺胁迫对野生酵母菌的抑制作用。

图7 Z5、Z5_A、Hl、Hl_A的多胺氧化酶活性
Fig.7 Polyamine oxidase activity of Z5, Z5_A, Hl and Hl_A
小写字母不同表示差异显著(P<0.05)。
相比之下,Z5_A显示出较低的多胺氧化酶活性(1.59 U/105 cell),但仍高于Hl_A,Z5在100 mg/L的生物胺胁迫下的多胺氧化酶活性比Hl高1.83 倍。这表明,尽管生物胺胁迫对Z5产生了一定的影响,但Z5在诱变后的胁迫耐受性和代谢能力仍优于Hl。这也表明诱变菌株对胁迫的适应性和降解能力较强。这种差异与转录组数据显示的胺降解相关基因(如ALD5、FMS1等)表达上调有关,同时代谢组中多胺降解中间产物(如5-甲氧基吲哚乙酸)含量的升高也对此进行了进一步验证。FAD是酵母多胺氧化酶的核心辅因子,其结合稳定性直接影响酶活性。研究[21]表明,辅因子结合域的突变可增强FAD与酶的结合能力,从而提高氧化反应速率。这与Z5中观察到的氧化活性增强相呼应,说明人工选育改善了FAD结合域或活性位点的构象稳定性,提升了其对胺类底物的亲和力和降解能力。
2.5 转录组和代谢组关联分析
根据KEGG通路分析,与生物胺直接降解相关的通路主要集中在氨基酸代谢和其他氨基酸代谢中,包括精氨酸和脯氨酸代谢(ko00330)、赖氨酸降解(ko00310)、谷胱甘肽代谢(ko00480)和β-丙氨酸代谢(ko00410),这些通路均与多胺(腐胺、精胺、亚精胺和尸胺)相关。
如图8所示,人工选育酵母菌S. cerevisiae Z5在应激条件下表现出较强的亚精胺降解能力。在Z5_A与Hl的比较中,亚精胺(C00315)含量显著下降(FC=0.199),而5-氨基戊醛含量(C12455)显著上升(FC=1.620),表明FMS1基因在多胺降解中起直接作用。FMS1基因编码多胺氧化酶,是FAD依赖性黄素腺嘌呤二核苷酸酶家族的成员,催化多胺(如精胺和亚精胺)中二级氨基的氧化[22]。FMS1参与精胺和亚精胺氧化为1,3-二氨基丙烷、4-氨基丁醛和过氧化氢[23]。FMS1基因的表达在Hl_A与Hl(log2 FC=1.063)和Z5_A与Hl的比较中观察到的下调(log2 FC=0.577)代表对抗生物胺应激的保护机制,增强了菌株的耐受性。值得注意的是,S. cerevisiae Z5通过增强醛代谢更有效地清除多胺降解过程中产生的有毒醛类。相关研究[24]证实,FMS1的缺失会导致多胺积累、毒性增强和细胞生长抑制。

图8 S.cerevisiae Z5的多胺代谢通路图
Fig.8 Polyamine metabolic pathways of S.cerevisiae Z5
S. cerevisiae Z5获得了应激适应能力。在Z5_A与Hl的比较中,Z5_A中鹅肌肽(C01262)含量显著上升(FC=4.535),表明S. cerevisiae Z5的抗氧化能力在应激条件下反而得到提升。在Z5_A与Hl的比较中,Z5_A的泛酸(C00864)含量显著上调(FC=5.171),表明S. cerevisiae Z5代谢重构与氧化还原平衡的增强[25]。SPE3基因编码的亚精胺合酶催化腐胺转化为亚精胺,而SPE4编码的精氨合酶催化亚精胺转化为精胺。腐胺的消耗减少生物胺(如腐胺和尸胺)的积累,从而间接促进其降解。在应激条件下,SPE4和SPE3基因表达的显著上调表明,菌株通过增强多胺合成应对生物胺应激,这间接促进生物胺的降解。S. cerevisiae Z5中SPE4的表达量较低,但在应激条件下显著上调,可能反映了更有效的应激反应机制,从而提高了生物胺的降解效率。SPE4和SPE3基因表达的变化表明,多胺回流合成机制的激活有助于降低胺类积累风险并维持生理稳态[26]。醛脱氢酶(acetaldehyde dehydrogenase,ALDH)可将醛类化合物氧化为相应的羧酸,同时再生NAD+。在生物胺降解过程中,ALDH氧化生物胺代谢产生的醛类中间体,从而减少其毒性并有助于能量代谢。ALD5基因表达在生物胺应激下进一步上调(log2 FC=3.17),表明ALD5在S. cerevisiae Z5高效降解生物胺方面发挥关键作用。ALD5在酿酒酵母线粒体中发挥关键代谢功能,缺失将导致有毒醛类积累并抑制能量生成,其在癌细胞与氧化应激模型中的上调也与抗氧化防御机制相关[27]。
如图9所示,人工选育酵母S. cerevisiae Z5在生物胺应激下表现出一定的色胺降解能力,归因于ALD5基因表达的显著上调。色胺降解的中间体5-甲氧基吲哚乙酸水平增加,表明色胺降解途径的激活,导致5-甲氧基吲哚乙酸的产量增加。ALDH家族在吲哚醛清除中具有关键作用[28],表明ALD5基因在抗氧化应激、色氨酸代谢以及醛毒性缓解中的中心地位。在生物胺应激和人工选育中BNA4和KMO基因的上调表达表明,色氨酸代谢途径参与了色胺的降解。BNA4和KMO在调控NAD+水平和维持氧化还原平衡中具有关键地位,尤其是在氧化胁迫下[29]。S. cerevisiae Z5通过关键基因表达的调控和相关代谢途径的激活提高其色胺降解能力。单胺氧化酶催化伯胺和某些仲胺的氧化脱氨基。单胺氧化酶需要NAD+作为辅因子,将胺氧化为相应的醛。单胺氧化酶在非神经系统中具有外源性胺类降解功能[30]。在转录组中鉴定出的甘油醛-3-磷酸脱氢酶(EC:1.2.1.12),其主要功能涉及糖酵解途径,其催化甘油醛-3-磷酸转化为1,3-二磷酸甘油酸并将NAD+还原为NADH[31]。褚琪等[32]通过对热灭活植物乳植杆菌SGJ-24进行全基因组测序,鉴定出甘油醛-3-磷酸脱氢酶作为一种新的生物胺降解酶,是该菌株中生物胺降解的主要酶。

图9 S.cerevisiae Z5的色胺代谢通路图
Fig.9 Tryptamine metabolic pathways of S.cerevisiae Z5
3 结 论
研究发现,FMS1基因编码的多胺氧化酶在生物胺降解中起到了至关重要的作用,尤其是对于亚精胺和精胺的降解。代谢组分析则表明,人工选育酵母菌S. cerevisiae Z5通过调节多胺的代谢途径提高了其在胁迫条件下的生物胺降解效率。此外,谷胱甘肽代谢等关键代谢途径也在S. cerevisiae Z5的降胺过程中发挥了重要作用。在生物胺胁迫下,S. cerevisiae Z5通过增强醛代谢更有效地清除多胺降解过程中产生的醛类物质,从而降低生物胺对菌株自身的影响。S. cerevisiae Z5在100 mg/L生物胺胁迫下的多胺氧化酶活性比野生酵母S. cerevisiae Hl高1.83 倍。此发现进一步支持了人工选育酵母S. cerevisiae Z5作为一种有效的生物胺降解剂在食品生产中的应用潜力。未来可以进一步利用基因工程技术优化,如通过基因编辑技术靶向调控降胺相关基因的表达,进一步提高菌株的降胺效率和环境适应性。对该酵母菌降解生物胺机理的探索与应用不仅有助于发酵肉制品中生物胺的调控,还为开展微生物定向功能优化奠定了基础。
[1] COSTANTINI A, VAUDANO E, PULCINI L, et al.An overview on biogenic amines in wine[J].Beverages, 2019, 5(1): 19.DOI:10.3390/beverages5010019.
[2] 闫子康, 周杨凯鸣, 林颖, 等.食盐添加量对酸鱼发酵过程中理化特性和安全性的影响[J].肉类研究, 2024, 38(3): 10-17.DOI:10.7506/rlyj1001-8123-20240304-048.
[3] 李廷任, 赵金山, 臧金红, 等.传统发酵与接种发酵酸肉安全品质特性的分析[J].食品工业科技, 2022, 43(15): 257-264.DOI:10.13386/j.issn1002-0306.2021100085.
[4] 张立飞, 孙明浩, 华成黎, 等.发酵食品中生物胺的形成、检测及其防控策略的研究进展[J].食品与发酵工业, 2023, 49(3): 329-339.DOI:10.13995/j.cnki.11-1802/ts.030365.
[5] 吴春霞, 石有权, 杨雁, 等.乳酸菌接种发酵对耿马酸肉品质的影响[J].肉类研究, 2024, 38(11): 18-22.DOI:10.7506/rlyj1001-8123-20240806-201.
[6] 段雨帆, 钟嫒嫒, 肖愈, 等.一株具有降生物胺能力葡萄球菌的筛选及其降解特性[J].现代食品科技, 2023, 39(10): 104-112.DOI:10.13982/j.mfst.1673-9078.2023.10.1384.
[7] 鄢嫣, 杨明柳, 周迎芹, 等.不同发酵剂对发酵牛肉品质、风味特性和安全性的影响[J].中国食品学报, 2024, 24(4): 170-185.DOI:10.16429/j.1009-7848.2024.04.017.
[8] 曾玉雪, 罗惠波, 余东, 等.浓香型大曲中降解生物胺菌株的筛选及应用[J].食品与发酵工业, 2021, 47(8): 145-151.DOI:10.13995/j.cnki.11-1802/ts.025753.
[9] BÄUMLISBERGER M, MOELLECKEN U, KÖNIG H, et al.The potential of the yeast Debaryomyces hansenii H525 to degrade biogenic amines in food[J].Microorganisms, 2015, 3(4): 839-850.DOI:10.3390/microorganisms3040839.
[10] KANEHISA M, SATO Y, FURUMICHI M, et al.New approach for understanding genome variations in KEGG[J].Nucleic Acids Research, 2019, 47(D1): D590-D595.DOI:10.1093/nar/gky962.
[11] KANEHISA M, SATO Y, KAWASHIMA M, et al.KEGG as a reference resource for gene and protein annotation[J].Nucleic Acids Research, 2016, 44(D1): D457-D462.DOI:10.1093/nar/gkv1070.
[12] XING Z, TU B P.Mechanisms and rationales of SAM homeostasis[J].Trends in Biochemical Sciences, 2025, 50(3): 242-254.DOI:10.1016/j.tibs.2024.12.009.
[13] WU G Y.Amino acids: metabolism, functions, and nutrition[J].Amino Acids, 2009, 37(1): 1-17.DOI:10.1007/s00726-009-0269-0.
[14] MILLER-FLEMING L, OLIN-SANDOVAL V, CAMPBELL K, et al.Remaining mysteries of molecular biology: the role of polyamines in the cell[J].Journal of Molecular Biology, 2015, 427(21): 3389-3406.DOI:10.1016/j.jmb.2015.06.020.
[15] XUE C, LI G L, ZHENG Q X, et al.Tryptophan metabolism in health and disease[J].Cell Metabolism, 2023, 35(8): 1304-1326.DOI:10.1016/j.cmet.2023.06.004.
[16] BACHHAWAT A K, YADAV S.The glutathione cycle: glutathione metabolism beyond the γ-glutamyl cycle[J].IUBMB Life, 2018, 70(7):585-592.DOI:10.1002/iub.1756.
[17] QIN J F, KRIVORUCHKO A, JI B Y, et al.Engineering yeast metabolism for the discovery and production of polyamines and polyamine analogues[J].Nature Catalysis, 2021, 4(6): 498-509.DOI:10.1038/s41929-021-00631-z.
[18] KAVI KISHOR P B, HIMA KUMARI P, SUNITA M S L, et al.Role of proline in cell wall synthesis and plant development and its implications in plant ontogeny[J].Frontiers in Plant Science, 2015, 6:544.DOI:10.3389/fpls.2015.00544.
[19] PROKOPIEVA V D, YARYGINA E G, BOKHAN N A, et al.Use of carnosine for oxidative stress reduction in different pathologies[J].Oxidative Medicine and Cellular Longevity, 2016, 2016(1): 2939087.DOI:10.1155/2016/2939087.
[20] QIN S, ZENG X M, JIANG M, et al.Genomic and biogenic aminereducing characterization of Lactiplantibacillus planatraum JB1 isolated from fermented dry sausage[J].Food Control, 2023, 154:109971.DOI:10.1016/j.foodcont.2023.109971.
[21] CLAVERÍA-GIMENO R, VELAZQUEZ-CAMPOY A, PEY A L.Thermodynamics of cooperative binding of FAD to human NQO1:implications to understanding cofactor-dependent function and stability of the flavoproteome[J].Archives of Biochemistry and Biophysics,2017, 636: 17-27.DOI:10.1016/j.abb.2017.10.020.
[22] 倪秀梅, 杨涛, 方芳.生物胺降解酶研究进展及其应用[J].微生物学通报, 2021, 48(11): 4398-4411.DOI:10.13344/j.microbiol.china.210201.
[23] 宋雅琪.代谢工程改造谷氨酸棒杆菌高效合成β-丙氨酸[D].无锡:江南大学, 2024.DOI:10.27169/d.cnki.gwqgu.2024.000787.
[24] PEGG A E.Toxicity of polyamines and their metabolic products[J].Chemical Research in Toxicology, 2013, 26(12): 1782-1800.DOI:10.1021/tx400316s.
[25] VELAZQUEZ-ARELLANO A, DE J, HERNANDEZ-VAZQUEZ A.Vitamins as cofactors for energy homeostasis and their genomic control,with special reference to biotin, thiamine, and pantothenic acid[M]//DE CATERINA R, ALFREDO MARTINEZ J, KOHLMEIER M.Principles of nutrigenetics and nutrigenomics.New York: Academic Press, 2020: 271-277.DOI:10.1016/B978-0-12-804572-5.00035-5.
[26] AGOSTINELLI E.Biochemical and pathophysiological properties of polyamines[J].Amino Acids, 2020, 52(2): 111-117.DOI:10.1007/s00726-020-02821-8.
[27] 高松林, 韦柳婷, 温文建, 等.基于数据挖掘和生物信息学探讨专利中药复方治疗酒精性肝病的用药规律及作用机制[J].科学技术与工程, 2024, 24(25): 10715-10725.
[28] RODRÍGUEZ-ZAVALA J S, CALLEJA L F, MORENO-SÁNCHEZ R,et al.Role of aldehyde dehydrogenases in physiopathological processes[J].Chemical Research in Toxicology, 2019, 32(3): 405-420.DOI:10.1021/acs.chemrestox.8b00256.
[29] MOR A, TANKIEWICZ-KWEDLO A, KRUPA A, et al.Role of kynurenine pathway in oxidative stress during neurodegenerative disorders[J].Cells, 2021, 10(7): 1603.DOI:10.3390/cells10071603.
[30] SHIH J C, THOMPSON R F.Monoamine oxidase in neuropsychiatry and behavior[J].American Journal of Human Genetics, 1999, 65(3):593-598.DOI:10.1086/302562.
[31] 黄超东, 李冰涛, 张启云, 等.基于血清代谢组学的中医气虚体质代谢特征研究[J].中药药理与临床, 2022, 38(5): 131-136.DOI:10.13412/j.cnki.zyyl.20220325.001.
[32] 褚琪, 张艳芳, 周浩然, 等.L. plantarum SGJ-24全基因组测序及活性相关基因的挖掘和分析[J].食品工业科技, 2024, 45(14): 131-138.DOI:10.13386/j.issn1002-0306.2023080245.